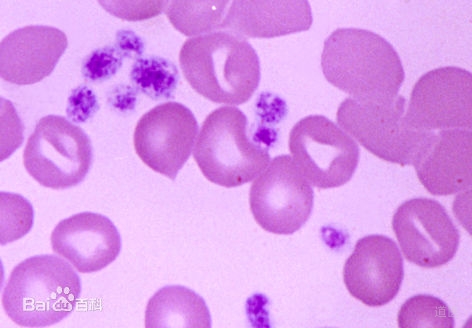
血小板减少如何治疗？民间验方牛皮胶疗效佳

周某,女,38岁,成都市某厂干部。初诊:1977年7月8日。于1974年5月开始头晕乏力,全身皮肤出现大小不等、密集成团的紫红色出血点,不痛不痒,按之不褪色,并伴牙龈、口腔出血,晨起漱口,出血尤甚。曾在中国医学科学院简阳分院附属血液病研究所作骨髓穿刺检查,诊断为原发性血小板减少性紫癜。一直服用激素、利血生、保肝..
血不归经阴血虚,身起瘀斑青紫色。疲倦乏力面黄白,盗汗心烦手足热。查血血小极减少,或有鼻衄齿衄血。和血止血滋阴血,生地鳖甲归藕节。麦冬白芍五味子,阿胶地榆鹤小蓟。出血较多加三七,心烦不寐连莲子。食欲不振加橘皮,山楂神曲鸡内金。方药:二甲复脉汤加减:生地15g 醋鳖甲10g 当归10g 麦冬10g 鲜藕节20g 白芍10g 地..
血减紫癜因血热,常于感染后突发。出血广泛出血重,烦躁不安脉弦数。便秘尿赤舌质红,凉血清营解毒热。广角生地银花连,丹皮赤芍粉丹皮。竹叶玄参翘麦冬,栀子茅根生侧柏。方药:清营汤加减:广角15g 生地15g 粉丹皮10g 丹参10g 赤芍9g 金银花20g 川连3g 竹叶6g 鲜茅根20g 玄参10g 连翘10g 生侧柏10g 麦冬10g 栀子9g注:此..
血不循经因气虚,反复出血周身斑。齿衄鼻衄面苍白,头晕目眩体倦疲。唇甲不华食不振,振颤多汗更心悸。经多舌淡脉细弱,动则气短心跳甚。益气摄血养心脾,加减归脾汤最宜。参茯术草木黄芪,当归远志焦枣仁。阿胶艾叶龙眼肉,小蓟百合焦地榆。肾虚腰酸小便频,巴戟骨脂淫羊藿。出血过多灶心土,煎汤代水来温脾。方药:归脾汤..
阴虚内热血妄行,皮肤紫斑多且稠。潮热心烦渴喜饮,出血量多色鲜明。手足心热腰酸软,脉象细数舌干红。养阴清热凉止血,加减茜根散白芍。阿胶生地侧柏叶,元参丹皮归黄芪。方药:茜根散加减:茜草根10g 白芍13g 生地15g 侧柏叶10g 阿胶12g(烊化) 元参10g 丹皮10g 当归8g 黄芪13g注:热耗阴液,灼伤脉络,迫血妄行,溢瘀皮..
血减紫癜出血症,血溢皮肤成紫斑。中医皮肤出血症,红疹肌衄和发斑。外感邪热阳热盛,情志郁结食不节。内伤阴虚生内热,热扰血分血妄行。溢于脉外遂出血,瘀于皮肤发紫斑。注:血小板减少性紫癜是一种以出血为主要表现的疾患。皮肤出血者,归属中医“红疹”、“肌衄”和“发斑”范围。平素情志抑郁,饮食不节,内伤正气,体..
张xx,女,5岁。〔主证〕病已半年,患儿于1974年7月开始鼻衄,于8月全身出现状如核桃及黄豆大紫斑,斑不疼痛,当时查血小板仅有10¹⁰/升,住北京×××医院用强的松治疗,最多量每日达23.5毫克,血小板上升至115×10⁹/升,但不能停减激素,强的松减至每日5毫克时,血小板又降至15×10⁹/升,鼻衄紫癜又出,被迫再增加强的..
血减紫癜有两型,热病继发和原发。热毒不尽阴耗动,血虚脉遏血离经。原发素体阴血虚,内热阴血不循经。注:热性病以后,热毒不尽,耗阴动血,一方面是热毒深入血分,壅遏脉道,迫使血离经脉。另一方面是热毒深入,耗伤阴血,阴虚血热,更增加出血机会。此种类型,既有毒热,又有阴虚,症属半虚半实。另一种类型是阴血不足,..

关老善用民间验方牛皮胶升血小板,通过多年实践证明,用于治疗血小板减少证有较好的疗效。临床中有在辨证论治处方用药的基础上配伍运用者,亦有单独运用而取得良好疗效者,此方制作简单,药源广泛,值得临床推广。牛皮胶系民间验方,其制法如下:取新鲜牛皮(不拘量)去毛,洗净用绞肉机绞碎后,用清水煎熬成稀胶状,以无皮..

虎杖一味,近年颇为医者赏识,不仅以其具有广谱的抑菌作用,且有降血脂,通络止痛,以及排石,止血等效用。文献中提到虎杖苷可引起白细胞总数减少。颜老历年来有意识对虎杖作了系统观察和分析,发现虎杖还具有平衡周围血象之升降的作用,初在感染性疾病的治则中恒加虎杖15g,如治肺炎,胆囊炎等疾患,确能使白细胞总数下降...
血小板减少性紫癜可能由免疫异常、感染、药物因素、遗传因素、骨髓造血功能异常等原因引起,临床表现为皮肤黏膜出血点、瘀斑、鼻出血等症状。可通过糖皮质激素治疗、免疫球蛋白输注、血小板输注、脾切除术、促血小板生成药物等方式干预。1、免疫异常免疫性血小板减少症是最常见类型,机体产生抗血小板自身抗体导致血小板破..